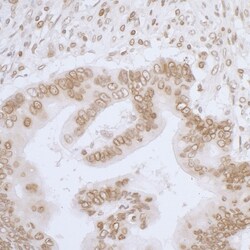
Novus Biologicals Thymopoietin/LAP2 Antibody, Novus Biologicals 100 &mu;g,

missing translation for 'onlineSavingsMsg'
Learn More
Learn More
Novus Biologicals™ Thymopoietin/LAP2 Antibody, Novus Biologicals™
Rabbit Polyclonal Antibody
Brand: Novus Biologicals™ NBP3-29536
This item is not returnable.
View return policy
Description
Thymopoietin/LAP2 Polyclonal antibody specifically detects Thymopoietin/LAP2 in Human,Mouse samples. It is validated for Immunohistochemistry,Immunoprecipitation,Western Blot
Specifications
| Thymopoietin/LAP2 | |
| Polyclonal | |
| Tris-citrate/phosphate pH 7 -8. | |
| Rabbit | |
| Affinity purified | |
| RUO | |
| Primary | |
| Human, Mouse | |
| Purified |
| Immunohistochemistry, Immunoprecipitation, Western Blot | |
| Unconjugated | |
| CMD1T, lamina-associated polypeptide 2, LAP2PRO0868, LEM domain containing 4, LEMD4, MGC61508, thymopoietin, Thymopoietin isoform alpha, Thymopoietin, isoforms beta/gamma, Thymopoietin-related peptide isoform alpha, Thymopoietin-related peptide isoforms beta/gamma, TP, TP alpha, TP beta/gamma, TPRP isoform alpha, TPRP isoforms beta/gamma | |
| Between 1 and 50 | |
| 100 μg | |
| DNA Repair, DNA replication Transcription Translation and Splicing | |
| 7112 | |
| Store at 4°C. Do not freeze. | |
| IgG |
Product Content Correction
Your input is important to us. Please complete this form to provide feedback related to the content on this product.
Product Title
Spot an opportunity for improvement?Share a Content Correction